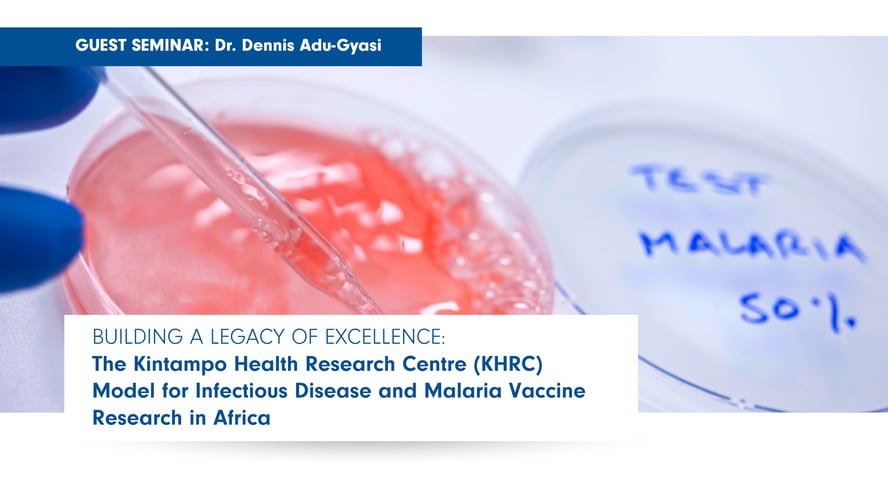
Guest Seminar: Dr. Dennis Adu Gyasi

Building a Legacy of Excellence:
The Kintampo Health Research Centre (KHRC) Model for Infectious Disease and Malaria Vaccine Research in Africa
Join Dr. Dennis Adu-Gyasi of KHRC, Ghana as he discusses the leadership role that the KHRC played to bring the RTS’S Malaria vaccine to licensure, now one of the EPI vaccines in Ghana and other African Countries.
Join in person or online
November 13, 2025 | 12:30 p.m. – 1:30 p.m
Tupper Medical Building, Theatre D
Pizza lunch to follow.
Virtual: Teams Meeting Link
Dr. Dennis Adu-Gyasi is a Research Fellow with the KHRC and the West African Postgraduate College of Medical Laboratory Science, with expertise in infection and immunity, clinical trials, pharmacokinetic and pharmacodynamics of therapeutic products